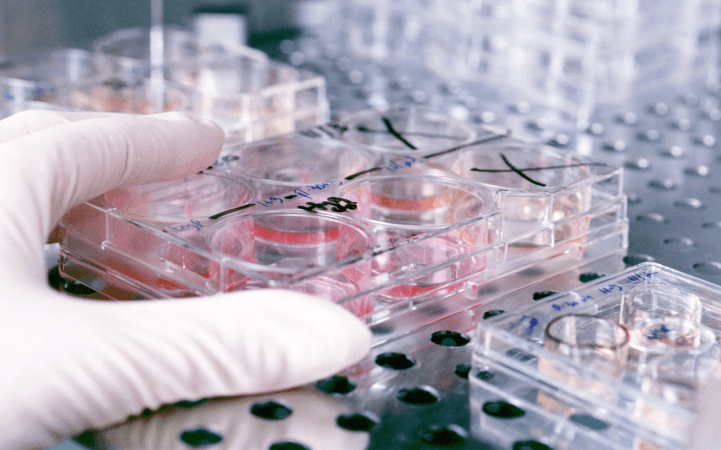

Антимикробные порошковые краски
Серебристо-ионная технология препятствует росту микробов, грибков и водорослей.
PPG Industries недавно опубликовала сведения о преимуществах линейки порошковых антимикробных красок, которые она выкупила у Spraylat в конце декабря прошлого года. Так, серебристо-ионная технология, использованная при создании рецептур ЛКМ, препятствует росту микробов, грибков и водорослей.
Такие материалы могут использоваться в сферах, требующих исключительной чистоты, к примеру, в медицинских учреждениях, системах водоочистки, фармацевтических лабораториях, детских садах. Большие перспективы для данных покрытий открываются в индустрии общественного питания.
По словам технологов PPG, составы могут быть заколерованы в любой цвет с использованием эпоксидных, полиэфирных или гибридных технологий.
Источник фото: drvora.com